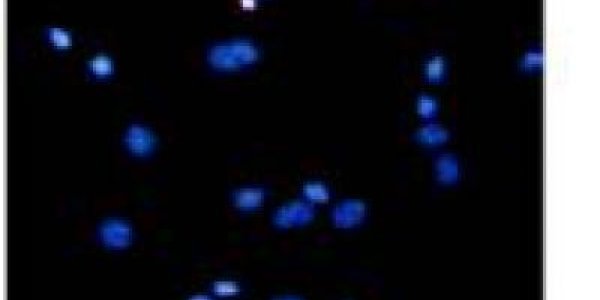
Study Finds Neuroprotective Effects Of Asiaticoside

Monthly Transfusions Reduce Silent Strokes In Kids With Sickle Cell Anemia
Silent strokes are a loss of blood flow to parts of the brain. Such strokes do not cause immediate symptoms and typically go undiagnosed, but they cause damage. In kids, they can even lower IQ.…